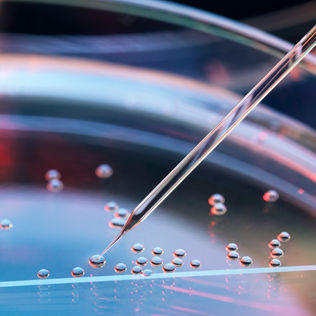
961109594

Skip to main content
- Insights
- Capabilities
- Sustainability
- About Us
- Careers
- My Account
Explore our insights
Asset class
Formats
Asset class
Investment Solutions
Sustainable Investing
Stewardship Principles
Investment Solutions